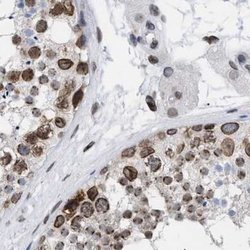
Invitrogen TPR Polyclonal Antibody 100 &mu;L; Unconjugated:Antibodies,

missing translation for 'onlineSavingsMsg'
Learn More
Learn More
Invitrogen™ TPR Polyclonal Antibody
Rabbit Polyclonal Antibody
Brand: Invitrogen™ PA554049
This item is not returnable.
View return policy
Description
Immunogen sequence: RDEEVSSADI SSSSEVISQH LVSYRNIEEL QQQNQRLLVA LRELGETRER EEQETTSSKI TELQLKLESA LTELEQLRKS RQHQMQLVDS IVRQRDMYRI LLSQTTGVAI PLHASSLDDV SLASTPKRPS TSQTVSTPAP Highest antigen sequence identity to the following orthologs: Mouse - 91%, Rat - 92%.
Steroidogenic factor-1 (SF-1) regulates multiple genes involved in the adrenal and gonadal development and in the biosynthesis of a variety of hormones, including adrenal and gonadal steroids, anti-Mullerian hormone (AMH), and gonadotropins. SF-1 belongs to the fushi tarazu factor-1 (FTZ-F1) subfamily of orphan nuclear receptors. In the adult ovary, SF-1 localizes to theca/interstitial cells.
Specifications
| TPR | |
| Polyclonal | |
| Unconjugated | |
| TPR | |
| 2610029M07Rik; C77892; Megator; NPC-associated intranuclear protein; nuclear pore complex-associated protein Tpr; nucleoprotein TPR; nucleoprotein TPR-like protein; Tpr; translocated promoter region (to activated MET oncogene); translocated promoter region and nuclear basket protein; Translocated promoter region protein; translocated promoter region, nuclear basket protein; tumor potentiating region | |
| Rabbit | |
| Antigen affinity chromatography | |
| RUO | |
| 7175 | |
| Store at 4°C short term. For long term storage, store at -20°C, avoiding freeze/thaw cycles. | |
| Liquid |
| Immunohistochemistry (Paraffin), Western Blot, Immunocytochemistry | |
| 0.1 mg/mL | |
| PBS with 40% glycerol and 0.02% sodium azide; pH 7.2 | |
| P12270 | |
| TPR | |
| Recombinant protein corresponding to Human TPR. Recombinant protein control fragment (Product #RP-91827). | |
| 100 μL | |
| Primary | |
| Human | |
| Antibody | |
| IgG |
Product Content Correction
Your input is important to us. Please complete this form to provide feedback related to the content on this product.
Product Title
Spot an opportunity for improvement?Share a Content Correction